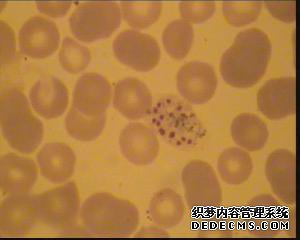

365bet体育备用网站
[虚拟疟疾消失]
作者:365bet娱乐城 发布时间:2019-09-30
幽灵疟疾
[疟疾鬼]疟疾。
在古代,迷信是由于这种疾病是由疟疾引起的。
唐李尚印的一首“野”诗:“幽灵疟疾进入王朝,增加了一个寒冷的春夜。
“见疟疾。”
[早晨]每天,每天。
《列子中妮》:“孩子们有点模糊。
“ Jan Gambao” Sou Shen Ji第13卷:皇帝的摇篮曲开始:“血液流过城门,城市不仅仅局限于湖泊。
“有一段历险,请看朝代。
诗歌《唐门浩然》留王景:《寂静在哪里?我将回到王朝。“
元旦“手帕”的第一折:“樱云去朝鲜,青山未活跃”
蔡东宣徐玉福的《中华民国通史》分别是第5和第6。
其中一首诗是《朱德的苦热》:“雨后,去小峰,慢慢地安静地爬。”
“

[疟疾鬼]疟疾。
在古代,迷信是由于这种疾病是由疟疾引起的。
唐李尚印的一首“野”诗:“幽灵疟疾进入王朝,增加了一个寒冷的春夜。
“见疟疾。”
[早晨]每天,每天。
《列子中妮》:“孩子们有点模糊。
“ Jan Gambao” Sou Shen Ji第13卷:皇帝的摇篮曲开始:“血液流过城门,城市不仅仅局限于湖泊。
“有一段历险,请看朝代。
诗歌《唐门浩然》留王景:《寂静在哪里?我将回到王朝。“
元旦“手帕”的第一折:“樱云去朝鲜,青山未活跃”
蔡东宣徐玉福的《中华民国通史》分别是第5和第6。
其中一首诗是《朱德的苦热》:“雨后,去小峰,慢慢地安静地爬。”
“